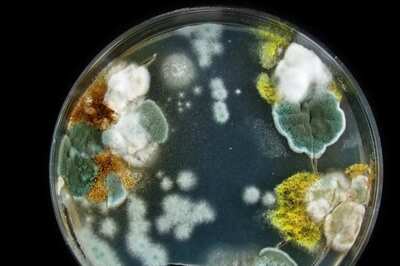
Will Fungal Infections Result In A 'Silent Pandemic'? What We Know

Lifestyle
Shardiya Navratri 2024: What Bhog Should Devotees Offer To Mata Shailputri On Day 1
Goddess Shailputri is believed to be the divine daughter of the Himalayas.
Happy International Coffee Day 2024: Wishes, Messages, and Quotes to Celebrate Your Love for Coffee!
As we celebrate International Coffee Day 2024, let’s share heartfelt wishes, uplifting messages, and inspiring quotes that reflect our love for coffee.
World Heart Day 2024: 10 Myths And Facts About Heart Disease
Let's seize the chance to dispel common myths about heart disease and arm people with the knowledge they need to safeguard their hearts.
Navigating Love Across Miles: 6 Simple Tips For A Successful Long-Distance Relationship
Long-distance relationships require love, trust, reassurance, time and above all, patience to survive.
Will Fungal Infections Result In A 'Silent Pandemic'? What We Know
A latest Lancet study has now urged to pay close attention to fungal infections, which can very well emerge as a ‘silent pandemic’.
Samantha Ruth Prabhu Goes All Glam With Her Outfits For Promotions Of Her Next
The actress opted for a navy-blue strapless dress in one of the photos.
Understanding Key Difference Between Heart Attacks, Cardiac Arrest, And Stroke: Causes, Symptoms And Treatments
Knowing the basics of these illnesses and how to identify their signs can be crucial in preventing death.
Navratri To Karva Chauth, A Look At Festivals In October 2024
Shardiya Navratri will be observed on October 3. It is celebrated with great devotion across India.
Eating A Balanced Diet And Managing Stress: 10 Heart-Healthy Habits For Kids
Take care of your child’s heart health by creating habits that will benefit them later in life.
Sonam Kapoor Blends Goth And Bohemian Flair Like A Pro At The Paris Fashion Week
Sonam Kapoor blended gothic and bohemian aesthetics for her look at the Paris Fashion Week. The actor was styled by Rhea Kapoor.
6 Best Alternatives To White Rice That You Must Know
Due to its high carb content, many people, especially those who are trying to cut on carbs and shed a few kilos, tend to avoid having white rice.
Rhea Singha’s Miss Universe India 2024 Winning Post Has A Coldplay Reference
After Rhea’s triumphant win, the Miss Universe Instagram page celebrated her momentous achievement with the perfect soundtrack – Coldplay’s The Universe
Beauty for All Skin Types: A Commitment to Inclusivity in Skincare
Creating skincare solutions that celebrate diversity while delivering luxurious, effective results for all is the need of the hour.
Discover Goa, Beyond The Beaches
Dive into this guide to explore some of Goa’s most extraordinary spots that will show you the best of the state, in a whole new light.
Aditi Rao Hydari Chooses Pink Anarkali Suit For First Appearance With Siddharth Post-Wedding
Aditi Rao Hydari and Siddharth were spotted at the Mumbai airport after their intimate wedding. The couple opted for easy-breezy outfits for the airport.
Pitru Paksha 2024: Know Important Rituals To Follow After Offering Pind Daan
According to traditional beliefs, several practices can help in obtaining the blessings of ancestors.